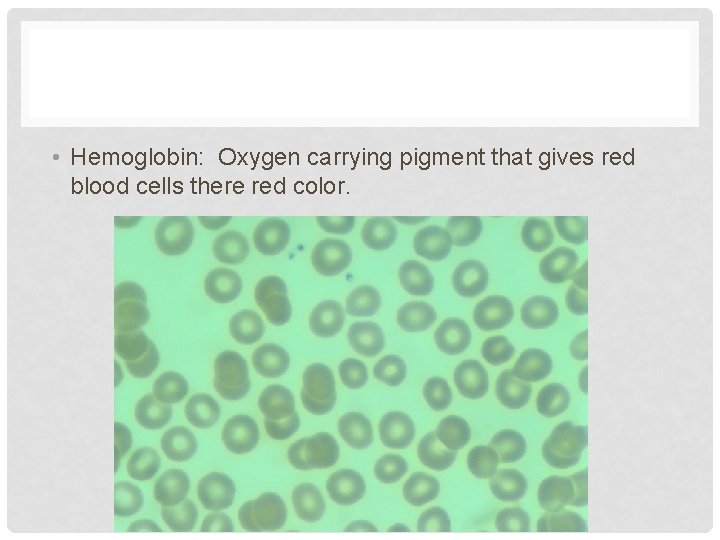
• Hemoglobin: Oxygen carrying pigment that gives red blood cells there red color.

MT LESSON 6 CBC COMPLETE BLOOD CELL COUNT

MT LESSON 6

CBC = COMPLETE BLOOD CELL COUNT

ESR = ERYTHROCYTE SEDIMENTATION RATE • The rate at which red blood cells settle in the blood with anticoagulant.

RBC = RED BLOOD CELLS • Contain hemoglobin and carry oxygen to the cells. •

WHITE BLOOD CELLS

PLT = PLATELETS • Involved in clotting the blood; thrombocytes

IBC = IRON BINDING CAPACITY • An iron test is done on the blood to see how iron is being metabolized. Fe needed for hemoglobin, the protein in red blood cells that carries oxygen.
• Hemoglobin: Oxygen carrying pigment that gives red blood cells there red color.

HEMATOTRIT • Hematocrit – A centrifuge for separating the cells of the blood from the plasma.

DIAGNOSIS • The process of determining the nature and cause of a disease

ARTERIAL BLOOD GASES • Important in measuring p. H and Oxygen and Carbon dioxide levels in the blood, helps to diagnose respiratory diseases.

PMN = POLYMORPHONUCLEAR NEUTROPHIL • A neutrophil, (white blood cell) that is granular.

AIDS = ACQUIRED IMMUN 0 DODEFICIENCY SYNDROME • -

K+ POTASSIUM • Silvery white metallic mineral, oxidizes in the air, used for fertilizer and hard glasses.

CALCIUM • Component of bone, skeletal mass, shells, necessary for nerve conduction, heart beat, muscle contraction.

R/O = RULE OUT

CHRONIC LYMPHOBLASTIC LEUKEMIA • Also know as Chronic lymphoid leukemia, excess white blood cells

AML = ACUTE MYELOGENOUS LEUKEMIA • Increases and unregulated growth of predominantly myeloid cells in bone marrow

BMT = BONE MARROW TRANSPLANT • Flexible tissue found in the hollow interior of the bones.

QNS = QUANTITY NOT SUFFICIENT

ECF = EXTRACELLULAR FLUID • All fluid outside of the cells, interstitual fluid and plasma constitute 20% of body weight.
- Slides: 21